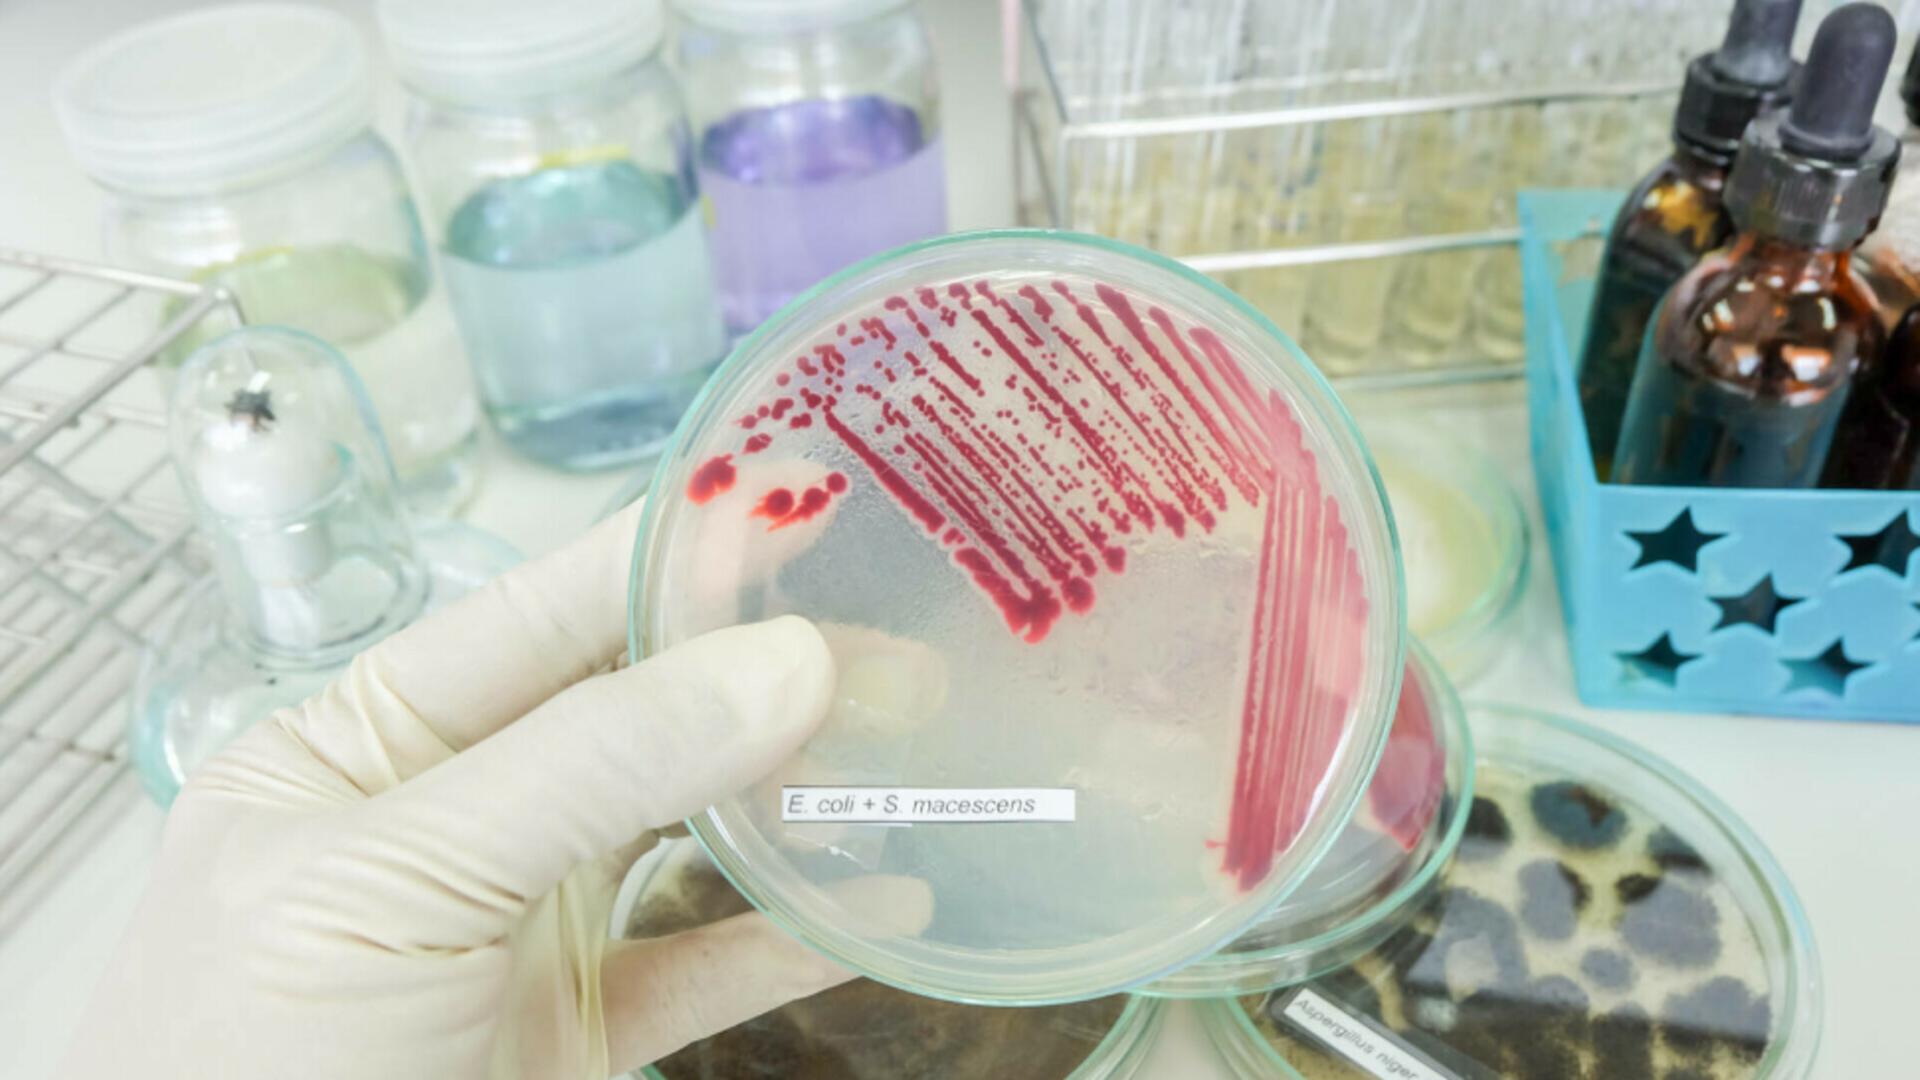
Cum putem preveni infecțiile nosocomiale și salva viețile copiilor: lecții după tragedia de la Iași

Tehnologia brevetată Polti Sani System, dezvoltată în colaborare cu mediul academic și validată prin teste independente, oferă o soluție concretă pentru reducerea riscurilor și crearea unui mediu medical mai sigur.
O tragedie care zguduie România
În ultimele săptămâni, România a fost cutremurată de știrea izbucnirii unui focar de infecții nosocomiale la Spitalul de Copii „Sfânta Maria” din Iași. Șase copii internați în secția de terapie intensivă au murit, iar investigațiile au scos la iveală prezența bacteriei Serratia marcescens, un agent patogen care poate provoca septicemii și pneumonii severe la pacienții vulnerabili.
Dincolo de anchetele oficiale și de declarațiile autorităților, această tragedie ridică o întrebare fundamentală: cum putem preveni ca astfel de drame să se repete?
Ce sunt infecțiile nosocomiale și de ce sunt atât de periculoase
Infecțiile nosocomiale – sau infecțiile asociate actului medical – sunt infecții pe care pacienții le contractează în timpul internării într-un spital sau al unui tratament medical. În România, problema este cronică: conform datelor OMS și ECDC, rata reală a acestor infecții este de 5-10 ori mai mare decât ceea ce se raportează oficial.
Aceste infecții:
- cresc durata spitalizării,
- măresc costurile medicale,
- consumă resurse suplimentare,
- și, cel mai grav, pot fi fatale, în special la pacienții vulnerabili – copii, nou-născuți, vârstnici, bolnavi imunodeprimați.
În spitalele europene moderne, prevenirea infecțiilor nosocomiale este o prioritate strategică. În România, însă, tragedia de la Iași arată că încă există lacune majore.
Vulnerabilitățile din spitale – unde se rupe lanțul siguranței
Focarul de la Iași a scos la iveală câteva probleme sistemice:
- Întârzierea raportării – prima infecție a apărut pe 13 septembrie, dar DSP a fost notificat abia pe 19 septembrie.
- Igienizare insuficientă – bacteriile se pot ascunde în zone greu accesibile, aparatură medicală sau medii umede.
- Lipsa de trasabilitate – nu există mereu dovezi clare despre cine a efectuat igienizarea și când.
- Resurse limitate – spitalele se bazează adesea pe metode clasice de curățenie și substanțe chimice care nu sunt suficiente.
- Toate aceste vulnerabilități creează condițiile perfecte pentru declanșarea unui focar.

Tehnologia Polti – o soluție testată și brevetată pentru prevenție
În fața acestei realități, există o întrebare simplă: cum pot fi prevenite infecțiile nosocomiale prin tehnologie modernă?
Răspunsul vine prin Polti Sani System, un sistem brevetat de dezinfectare cu abur supraincalzit (până la 180°C), dezvoltat în colaborare cu Facultatea de Medicină și Chirurgie a Universității din Pavia, Italia.
Caracteristici esențiale:
- Aburul este emis sub formă de nor fin, fără picături lichide, acoperind uniform suprafețele.
- Dezinfectare fără contact – suprafețele nu trebuie atinse, reducând riscul de contaminare încrucișată.
- Eficiență dovedită: elimină până la 99,999% din viruși, bacterii, ciuperci și spori.
- Trasabilitate completă: fiecare operațiune este înregistrată, cu raport imprimat și identificarea operatorului prin card RFID.
- Autonomie de lucru nelimitată: sistem de reumplere continuă, boiler inox ranforsat.
- Design ergonomic și mobilitate: ideal pentru utilizare zilnică în secții ATI, saloane și blocuri operatorii.
- Cum funcționează în practică
Spre deosebire de soluțiile chimice, care pot lăsa reziduuri sau nu ajung în toate zonele, aburul supraincalzit pătrunde în cele mai mici fisuri, eliminând agenții patogeni în doar câteva secunde.
Operatorul poate alege dintre 10 programe presetate, în funcție de dimensiunea spațiului sau a obiectului tratat. La final, imprimanta integrată emite un raport care atestă operațiunea, cu dată, oră și numele operatorului.
Această trasabilitate este un avantaj enorm: conducerea spitalului și DSP-ul pot verifica în orice moment cine, unde și când a efectuat igienizarea.
Studiu de caz – secțiile ATI
Secțiile de terapie intensivă sunt cele mai vulnerabile la infecții nosocomiale. Aici se găsesc pacienți critici, ventilați mecanic, cu sisteme imunitare fragile.
Un protocol zilnic de dezinfectare cu Polti Sani System ar putea reduce dramatic riscul de focar:
- suprafețele saloanelor,
- aparatura medicală,
- ventilatoarele,
- zonele greu accesibile.
Rezultatul? Un mediu sigur, controlat, unde bacteriile nu mai au șansa să se multiplice.
Beneficii pe termen lung
Implementarea unei astfel de tehnologii aduce beneficii clare:
- Pentru pacienți și familii: mai multă siguranță, mai puține tragedii.
- Pentru medici și asistente: reducerea riscului de contaminare și a presiunii emoționale.
- Pentru spitale: scăderea costurilor suplimentare, creșterea prestigiului.
- Pentru sistemul sanitar: încredere publică sporită și aliniere la standarde europene.
Concluzie – Avem soluția, trebuie doar să o aplicăm
Tragedia de la Iași nu trebuie să rămână doar o știre dramatică de presă. Trebuie să fie un punct de cotitură pentru întreaga Românie.
Infecțiile nosocomiale nu sunt un destin inevitabil. Ele pot fi prevenite prin tehnologie modernă, protocoale clare și responsabilitate instituțională.
Polti Sani System oferă deja această soluție, testată și certificată. Este momentul ca spitalele din România să adopte aceste tehnologii și să transforme promisiunea în realitate: niciun copil nu trebuie să mai moară din cauza unei infecții spitalicești prevenibile.